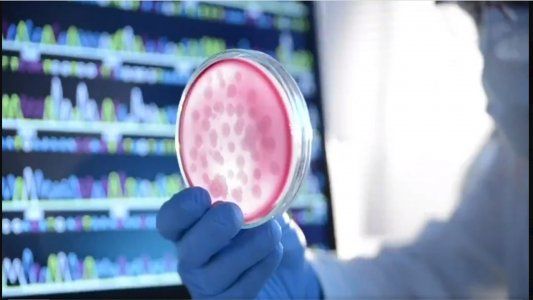
Pfizer reconoce que su vacuna baja significativamente la eficacia frente a la variante sudafricana del COVID y aleja la posibilidad de la inmunidad de rebaño

Las vacunas contra el Covid-19 fueron largamente esperadas durante un año. Desarrolladas en tiempo récord, su eficacia y duración sigue siendo fuente de polémicas, controversias y de estudios contradictorios.
Las vacunas contra el Covid-19 fueron largamente esperadas durante un año. Desarrolladas en tiempo récord, su eficacia y duración sigue siendo fuente de polémicas, controversias y de estudios contradictorios.
Un trabajo presentado este 17 de febrero, en la prestigiosa publicación "New England Journal of Medicine" dice que la vacuna de Pfizer, reduce su eficacia frente a la variante sudafricana del Covid-19.
El informe remarca que ante la mutación sudafricana, registrada como "B.1.351" logra una mayor resistencia frente a la vacuna. Tanto la de Pfizer como la de Moderna se basan en un ARN mensajero. Mediante ingeniería genética, se logra que el virus no logre que su "espícula Y" logre ingresar en una célula sana y la infecte.
Pero según este nuevo estudio, presentado entre otros por el doctor Pei-Yong Shi, tiene una mayor "habilidad" para sortear esa inhibición que busca la vacuna. El resultado: su eficacia baja ante la mutación sudafricana
Allí radica la gran duda de la comunidad científica. "La actividad contra esta variante se redujo en un margen significativo", señala el nuevo estudio.
Pero al mismo tiempo establece en su parte final que "no está claro si la reducción en la neutralización - aproximadamente en dos tercios, afecta la efectiva protección contra el SARS-COV-2".
El propio doctor Shi, de la Universidad de Texas, señala en el escrito que cree que la vacuna Pfizer probablemente protegerá contra la variante. "No sabemos cuál es el número mínimo de neutralización. No tenemos esa línea de corte", aclaró
A una conclusión similar llegó el laboratorio Moderna, que desarrolló el mismo tipo de vacuna.
Pero los científicos no se ponen de acuerdo ni siquiera en los foros especializados. Esta semana, en la revista "Nature" otra presentación dice que las vacunas contra Covid-19 son “ligeramente menos eficaces”.
Por lo que creen que tal vez, ante la aparición de esta o nuevas mutaciones, la vacuna deba ser "actualizada".
Eso es lo que justamente, permite con mayor facilidad la técnica del ARN mensajero. "Rediseñar" la vacuna para que se adapte a cada tipo de mutación y evite la infección de las células, por consiguiente, el contagio.
Como se ha hecho una costumbre, ante la novedad absoluta de las vacunas contra la pandemia, el doctor Shi advierte que "se necesita más trabajo para comprender si la vacuna funciona contra la variante sudafricana".